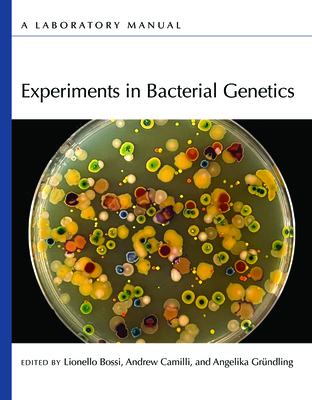

Bacteria are powerful systems for genetic research. They are fast growing and easy to propagate and maintain, and many tools have been developed for their genomic analyses and genetic manipulation. The study of bacteria and their viruses allowed deciphering the genetic code and has shaped our understanding of fundamental biological processes such as DNA replication, transcription, and translation.
This manual provides a collection of experimental procedures for genetic research in bacteria. It describes basic methods for the isolation and propagation of bacteria and phages, purification of genomic DNA and plasmids, and introduction of DNA into bacteria. Diverse strategies for generating and confirming mutations and for creating gene deletions and gene fusions are described, using allelic exchange, random transposition, recombineering, and CRISPR-Cas technologies. Protocols for bacterial genome sequencing and resequencing, as well as for high-throughput mutant screening via transposon sequencing, are provided.
Although specific bacterial species such as
Escherichia coli,
Salmonella enterica,
Vibrio cholerae, and
Staphylococcus aureus are used for some of the protocols, the methodologies herein described can readily be adapted for use with other bacteria. This manual thus represents a valuable resource for those seeking to perform genetic experiments in bacteria.